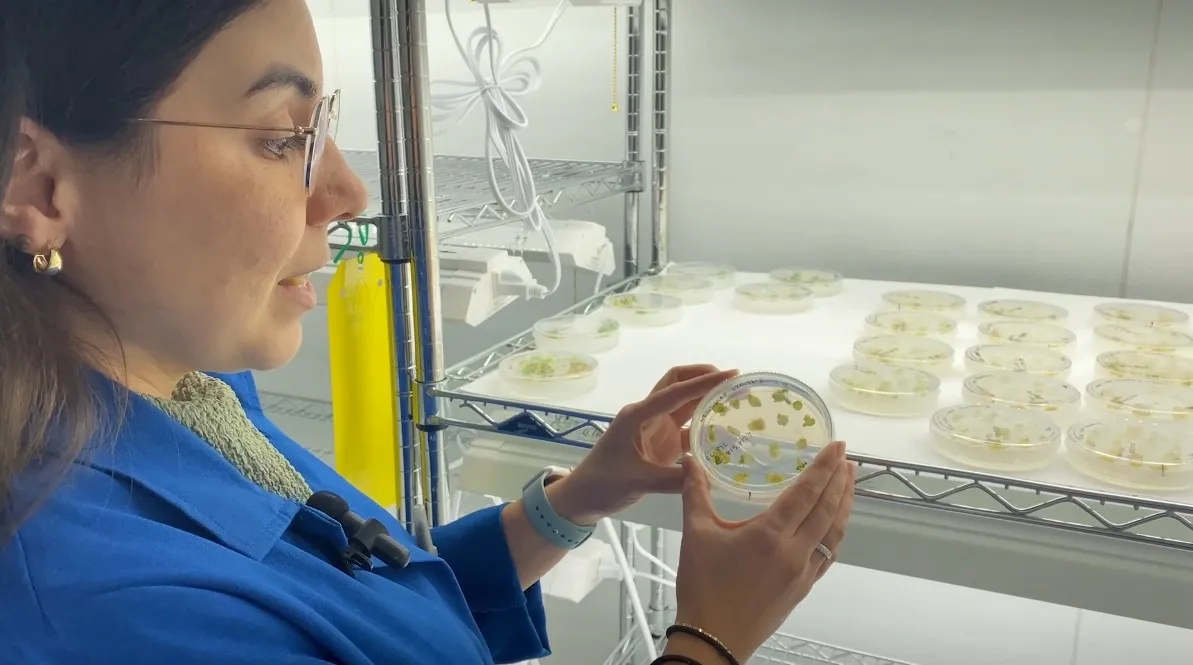

To train new people to work with California specialty crops and update the skills of current workers, educators from University of California, Davis and UC Agriculture and Natural Resources, Fresno State, Cal Poly San Luis Obispo, Chico State and five California community colleges are producing educational videos. The training video series is available to the public for free on YouTube at https://www.youtube.com/@jeffreymitchell759/playlists.
“As California’s farmers age, shortages of suitably trained agricultural workers increase, and workers increasingly come from non-farming backgrounds, the role of agricultural colleges in teaching both the theory and practice of agriculture is key today,” said Jeff Mitchell, UC Cooperative Extension specialist in the Department of Plant Sciences at UC Davis.
“The average age of agricultural producers in California is currently about 59.2 years,” said Mitchell, who is based at the UC Kearney Agricultural Research and Extension Center in Parlier in Fresno County. “Therefore, there is an urgent need to encourage and recruit young people into agriculture to sustain current and future production.”
It is also vitally important that those entering the workforce receive adequate training in current production practices of the state’s particularly dynamic specialty crop industries.
“In response to the growing demand for online education following COVID-19, I have strategically incorporated YouTube video clips – particularly those produced by UC Agriculture and Natural Resources – into my course material to enhance student engagement and learning outcomes,” said Sophia Marin, Bakersfield College adjunct professor. “One of the greatest challenges in teaching agriculture in a virtual setting is the inherently hands-on nature of the industry.”

Marin has been using videos produced a few years ago. The video curriculum series currently being developed includes integrated weed management, postharvest technology, crop breeding, microgreen production, soil management, labor and specialized farm machinery.
Many key concepts, especially those related to plant pathology and crop management, are difficult to fully convey through traditional textbooks or static images alone, Marin noted.
“To address this gap, I began supplementing my lectures with real-time video recordings captured during farm visits, with the consent of local growers,” she said. “These video clips provide students with invaluable exposure to real-world agricultural practices and allow them to observe phenomena such as plant diseases – including Southern Blight – in a way that is far more dynamic and informative than text-based descriptions.”
“Through visual media, students can see subtle distinctions in plant symptoms, understand how and why spores develop, and gain deeper insight into diagnostic and treatment processes,” Marin noted.

In addition to addressing current practices, the training video series also anticipates the challenges that producers will face.
Vegetable farmers – who tend to have greater labor needs than many in other agricultural sectors – face mounting worker shortages and need to modernize their farm workforce.
“Vegetable production systems need to be dynamic to keep pace with unpredictable economic, social, environmental and regulatory changes,” Mitchell said. “These systems must continually adapt to innovations and must have a workforce that understands and can implement ever-changing technologies.”
Visiting farms and viewing videos give Bakersfield College students a clearer idea of the kinds of jobs they would like to pursue, according to Marin.
“These professionally produced clips complement textbook topics such as urban agriculture, propagation, transplanting and field packing, offering students a visual context that supports their understanding of the material,” Marin said. “What I have noticed is these resources promote active learning: students tend to engage more deeply in discussion boards via Canvas, conduct independent research to supplement course content, and demonstrate increased confidence in both their academic progress and career aspirations.”
Development of the teaching modules to train workers for California’s vegetable crops industry is funded by the California Department of Food and Agriculture’s Specialty Crop Block Grant Program. The videos will be used and rigorously evaluated by the four universities and five community colleges that serve as key conduits for agricultural workers to the state’s vegetable production regions.
The first training video of the new series, “Contemporary and future approaches to plant breeding,” is available. New videos will be added at https://www.youtube.com/@jeffreymitchell759/playlists weekly until the 25-part series is complete.
Other project partners include Madera College, Merced College, Santa Rosa Community College, Hartnell College and Agriculture and Land-Based Training Association in Salinas.